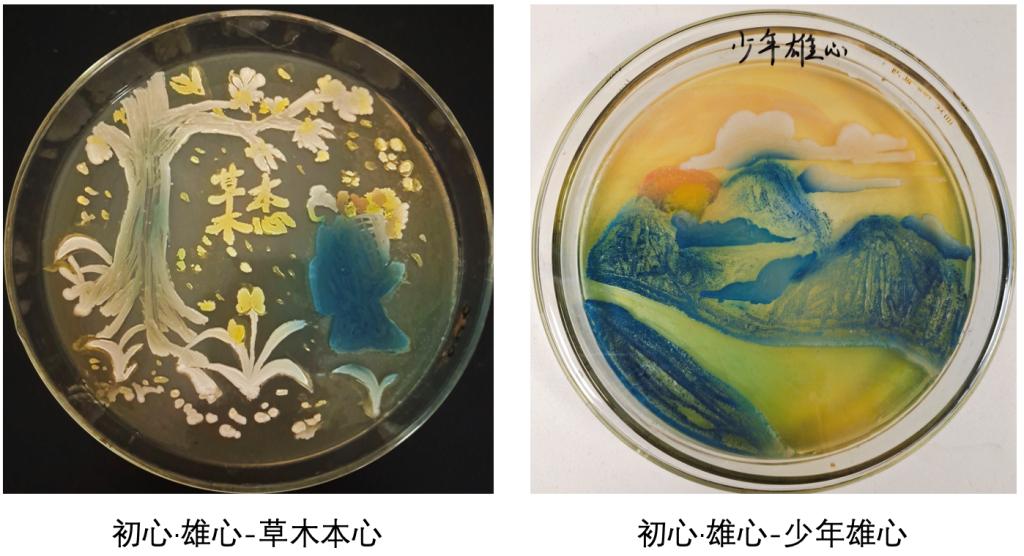

2022年11月28日,湖北省第一届微生物培养皿艺术设计大赛获奖名单出炉。华中科技老员工命科学与技术公司向大赛组委会提交16组作品中获得一等奖1项、二等奖1项、优秀奖4项。公司白虹老师、李辉老师、闫云君老师获评“优秀指导教师”。永利官网获评优秀组织单位。
湖北省第一届微生物培养皿艺术设计大赛的主题为“科学探索‘微’之美,青春献礼二十大”。大赛要求参赛团队依据大赛主题,通过微生物培养技术在培养皿上进行艺术创作,使在培养基上生长的、表达不同颜色的微生物组成各种各样积极向上的正能量图案,参赛者需对相关微生物的种类、生长情况、颜色情况等进行科学研究,以更好地利用微生物进行艺术创作,形成创意细菌画作品。该赛事主要考察参赛团队的微生物基本知识、基本实验操作能力和研究能力、艺术设计和创造能力等。
自今年7月31日大赛启动以来,yl7703永利实验教学中心积极动员师生参与,提供专用实验场地及实验材料。在指导教师的精心指导下,参赛员工利用所学微生物基础知识,围绕大赛主题,发挥创新精神,不断提高实验技术操作水平和提升生命之美艺术涵养,完成参赛作品。
各参赛小组成员根据自己的创意,分别选用红色和白色的酵母菌、黄色的嗜根考克氏菌以及灰白色的大肠杆菌等彩色菌种进行实验。通过探索微生物最适生长条件,如培养基成分及比例、培养温度、培养湿度、培养时间等,以及不同作画工具、不同菌液浓度对绘画结果的影响,确定最佳实验方案,最终呈现丰富多彩的微生物画作品。
获奖作品展示如下:
一等奖(1项)
作品名称:海的女儿
参赛员工:李忆欣、宁宇杰、张心怡
指导教师:李辉

二等奖(1项)
作品名称:梧桐听雨
参赛员工:刘天成、林子凯、胡宇痕
指导教师:白虹、闫云君

优秀奖(4项)
作品名称:重生·向阳
参赛员工:王晓娟、王龙、卓春萍
指导教师:余洪波

作品名称:当休明之盛世
参赛员工:田雪、李子龙、朱涛炜
指导教师:李辉

作品名称:初心·雄心
参赛员工:王雨婷、殷斯萌、罗可欣
指导教师:杨敏、廖贵芹
作品名称:发展之路
参赛员工:王雨婷、殷斯萌、罗可欣
指导教师:杨敏、廖贵芹

今年11月,华中科技老员工命科学与技术公司成功入选“湖北省科普教育基地”。公司将继续发挥科普基地育人优势,通过鼓励并组织员工参加各类科普创意竞赛,充分给予员工动手实践机会,提升员工实验操作能力,不断增强员工对“生命之美”的艺术鉴赏力和创造力,多维度激发员工钻研生命科学的志趣。